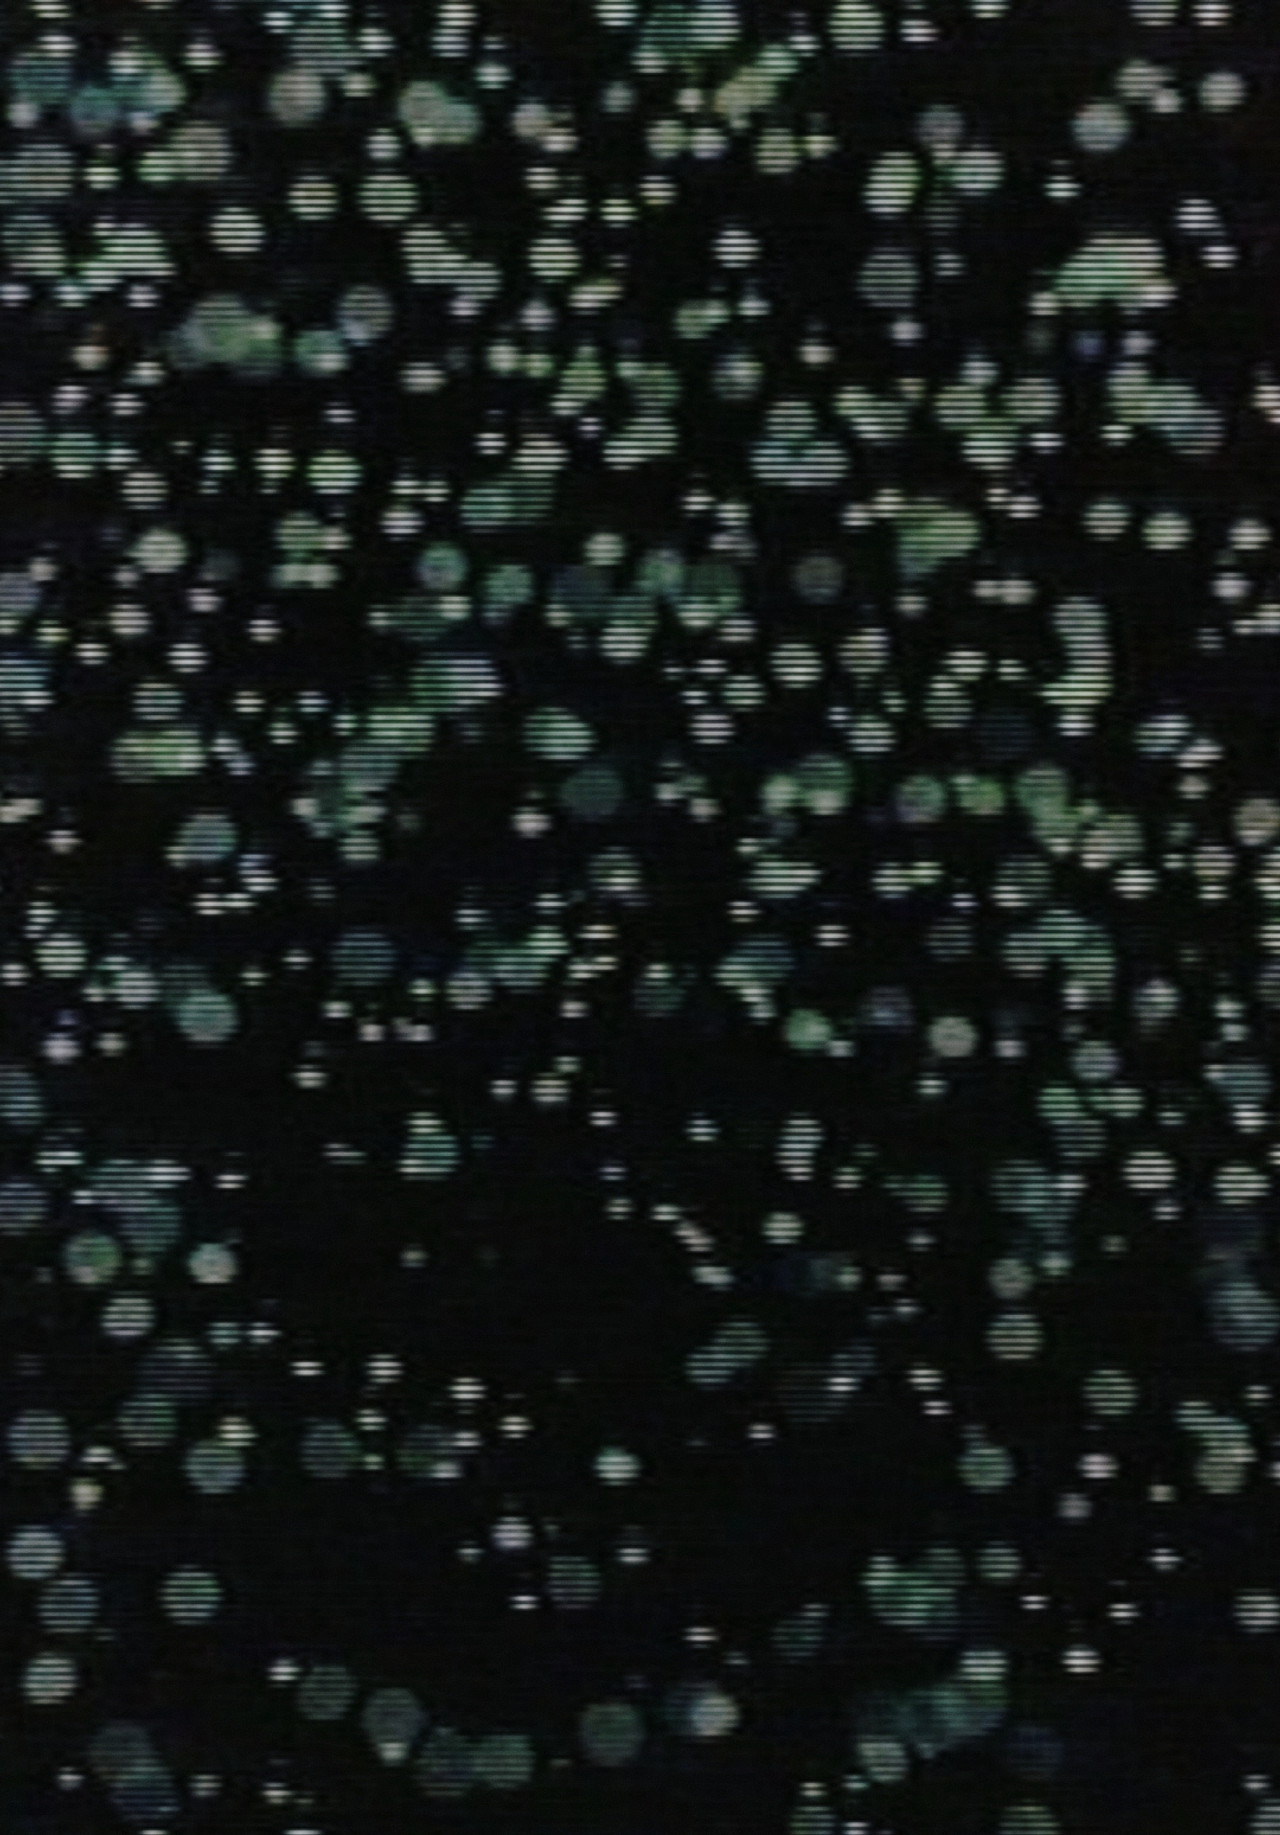
enlarged Poster 0

Motion
movie

Released January 01, 1980
Overview
Hiroshi Yamazaki, 16mm, 10'00.
Runtime
0h 10m
Origin Country
Japan
Original Language
Japanese
Original Title
Motion
Status
Released
Production Countries
- Japan
Spoken Languages
- No Language (No Language)
Cast
no credits available...
See All Credits